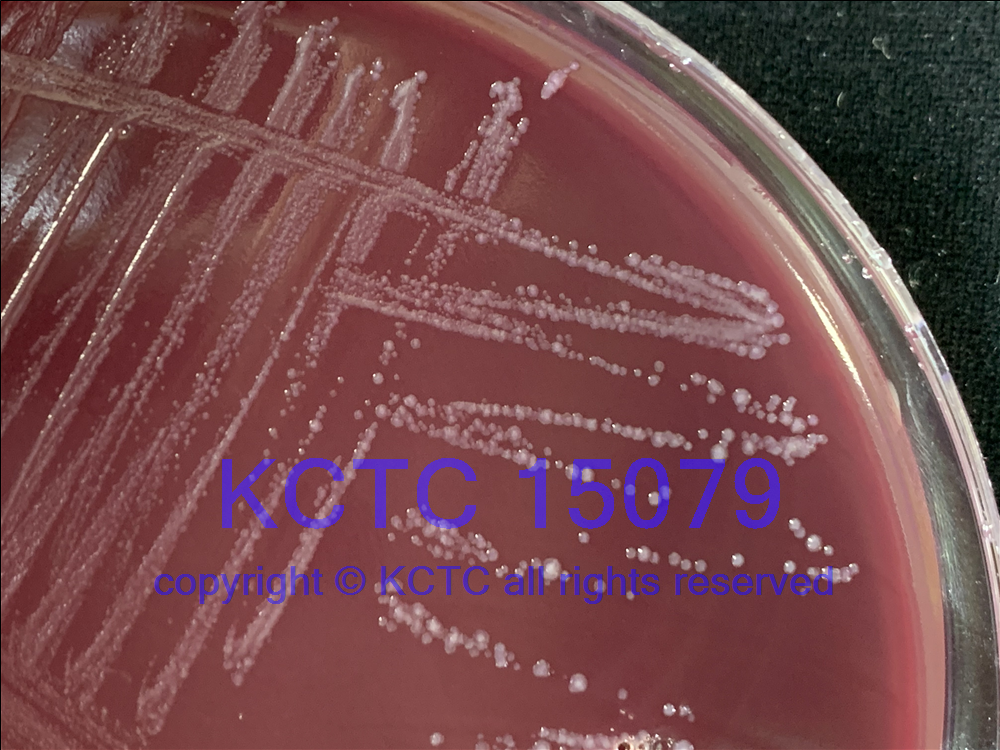

KCTC No. 15079
(KCTC Other No.)
Resource Type Bacteria
Name Leyella stercorea
Type Strain Yes
Biosafty Level 1
LMO No
Synonym Prevotella stercorea
Phylum (ex Phylum) Bacteroidota (Bacteroidetes)
Genome Information
NCBI Genome UID : GCA_000235885.1
History <- JCM <- H Hayashi, CB35
Source From human feces of a healthy Japanese male, 52?years old, Japan
Other Collection No. CB35, DSM [18206], JCM [13469]
Reference 10.1099/ijs.0.64778-0, 10.1016/j.syapm.2022.126354, 10.1099/ijsem.0.005709
KCTC Media No. KCTC media No. 282 Modified PYG-Medium + [5% Horse serum]
KCTC media No. 293 EG Medium
KCTC media No. 704 TSA HEMIN MENADIONE MEDIUM
KCTC media No. 766 COLUMBIA BLOOD AGAR WITH 5% SHEEP BLOOD
KCTC media No. 1806 FASTIDIOUS ANAEROBE BROTH
Oxygen Requirement Anaerobic
Temperature 37 ℃
pH netural pH ?? ?? (???? ??)
Incubation Time 3-7 d [???? ???? ????? ??, ?? ? ????? ??? ?? ?? ? ??]